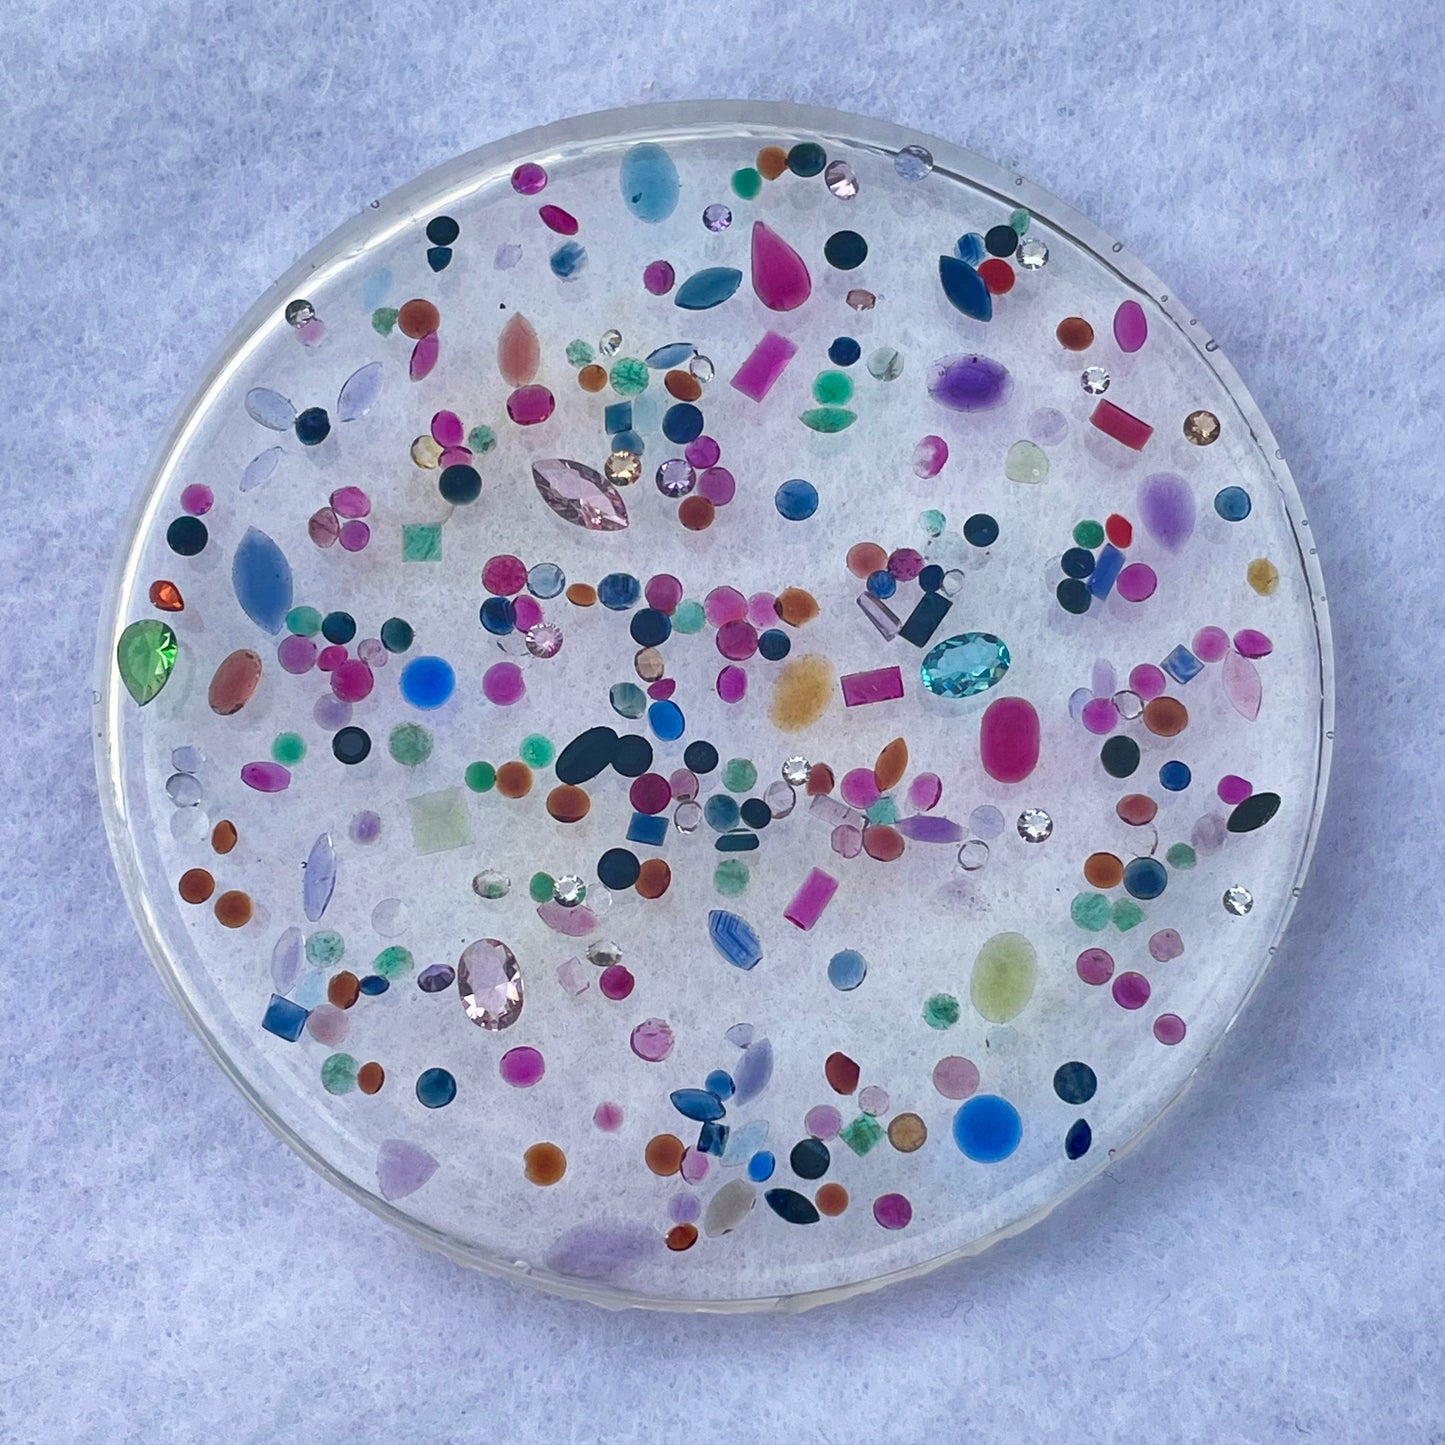

Recycled Gemstone Coaster
Recycled Gemstone Coaster
Couldn't load pickup availability
Looking for a way to add a little sparkle to your home? We always are which is why we decided to create gemstone coasters!
Now in three varieties!
Our standard rainbow mixed gemstone coaster featuring a colourful mix of gemstones. The colourless variety featuring CZ stones. And the black variety which is predominitely dark blue / black sapphire.
These resin coasters are sprinkled with sparkly recycled gemstones. They are handmade in the UK so no two coasters will be identical which is half the fun!
Set of 4 coasters for £75. Mix or match - add any 4 coasters to your cart and a £21 discount will be automatically applied!
The perfect gift for any gem lover - they can be used to study the immersion effect, as a fun way to try to recognise gemstones (look out for amazing colour zoning effects) and if you want to be practical they will keep your table safe from those pesky water rings.
Share